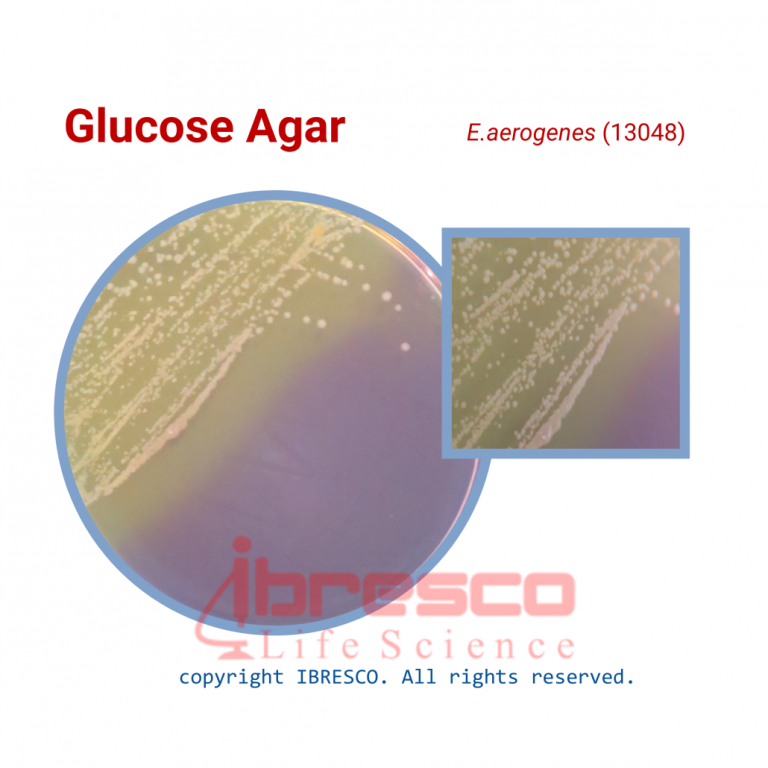
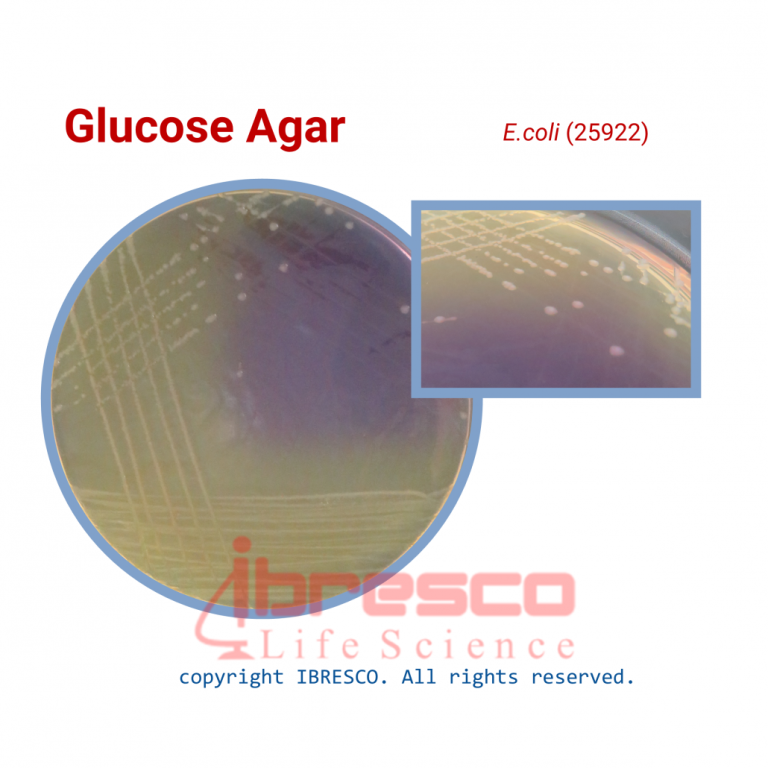

محیط کشت گلوکز آگار - برند ایبرسکو
0
0
محیط کشت افتراقی